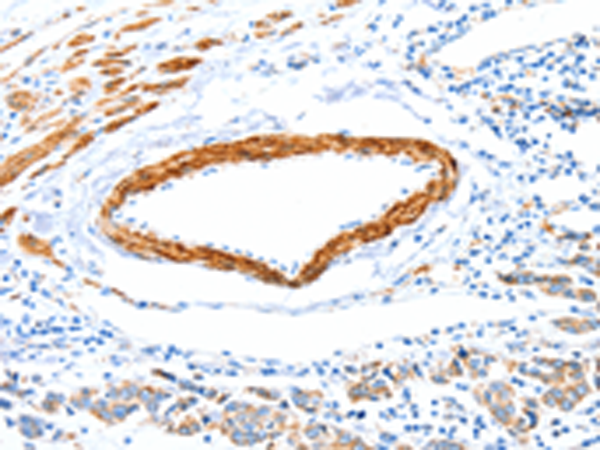

別 名: HMP, P87, P89, PIG4, PIG52, MINOS2, P87/89
儲 存: 冷凍(-20℃)
宿 主: Rabbit
技術(shù)規(guī)格
|
Background: |
Mitochondrial inner membrane protein is a protein that in humans is encoded by the IMMT gene.IMMT has been shown to interact with BAT2.The mitochondrial inner membrane (IM) serves as the site for ATP production by hosting the oxidative phosphorylation complex machinery most notably on the crista membranes. Disruption of the crista structure has been implicated in a variety of cardiovascular and neurodegenerative diseases. |
|
Applications: |
ELISA, WB, IHC |
|
Name of antibody: |
IMMT |
|
Immunogen: |
Fusion protein of human IMMT |
|
Full name: |
inner membrane protein, mitochondrial |
|
Synonyms: |
HMP, P87, P89, PIG4, PIG52, MINOS2, P87/89 |
|
SwissProt: |
Q16891 |
|
ELISA Recommended dilution: |
2000-5000 |
|
IHC positive control: |
Human colon cancer and Human breast cancer |
|
IHC Recommend dilution: |
15-50 |
|
WB Predicted band size: |
84 kDa |
|
WB Positive control: |
Hela and 231 cells |
|
WB Recommended dilution: |
500-2000 |

購物車
購物車 幫助
幫助
 021-54845833/15800441009
021-54845833/15800441009
